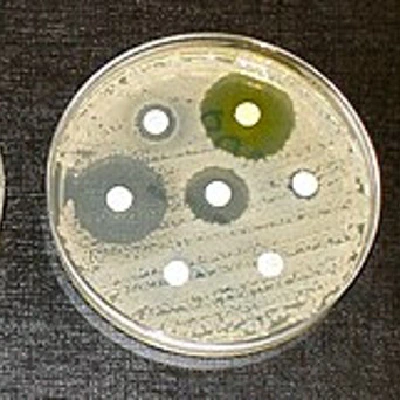
Risk of AMR in the environment

Our Work
Selected projects

A Road Map towards freedom from Lungsickness and FMD for the Northern Communal Areas of Namibia
Namibia 2012 - MAWF and DVS and US Millenium Fund
Breaking down the barriers caused by the Red Line – a veterinary cordon fence dividing North from South.
View Project
Avian Influenza: reports and dashboard
Europe - European Food Safety Authority (EFSA)
We have been developing information systems and decision-support tools to strengthen industry, national, regional and global animal health and production systems for the last 25 years.
View Project
Compartmentalisation and ASF
North America - A large integrated pork producer
Integrated production systems lend themselves well to compartmentalization for ASF purposes. The substantial investment produces many important benefits beyond ASF preparedness.
View Project
Context-specific definitions of epidemiological units
Europe - Pharmaceuticals & Animal Health
Balancing Regulatory Compliance with Commercial Reality
View Project
Crop pest and disease reporting and response system
Ghana - Bill & Melinda Gates Foundation, Grand Challenges Explorations Grant
We have been developing information systems and decision-support tools to strengthen industry, national, regional and global animal health and production systems for the last 25 years.
View Project
Data-driven control and prioritisation of endemic diseases
Europe - Public and private sectors
EpiMundi is an active member of DECIDE, a five-year Horizon 2020 project, aiming to develop data-driven decision support tools that offer robust and early signals of disease emergence and options for diagnostic confirmation.
View Project
Decision trees made easier
World wide - EpiMundi
We have developed the andorR R package to make the decision process easier and more efficient. The package address two key areas: confidence and optimisation.
View Project
Early Warning System for Avian Influenza
Europe - European Food Safety Authority (EFSA)
The Bird Flu Radar (GUI) has been developed for EFSA. It is based on a spatiotemporal risk assessment to estimate the probability of HPAI outbreaks in the wild bird population by spatiotemporal unit across Europe.
View Project
Integrated commercial data to empower salmon industry
Chile - Sernapesca
This project represented an integrated programme of applied epidemiological research into Salmon Rickettsial Syndrome (SRS) and Caligus in the Chilean aquaculture industry. The research sought to address many knowledge gaps about the causes of disease and the effectiveness of control measures. Ultimately, the goal was to improve the health, profitability and sustainability of the Chilean aquaculture industry, for the benefit of the Chilean environment, economy and people.
View Project
ISIKHNAS - Indonesia's national animal health and production system
Indonesia - AusAID
We have been developing information systems and decision-support tools to strengthen industry, national, regional and global animal health and production systems for the last 25 years.
View Project
Risk of AMR exposure via food products
United Kingdom - Food Standards Agency UK
This work sought to enable the production of more efficient and reproducible AMR risk assessments, as relevant steps in the food chain are available “off the shelf” and allow to facilitate collaborative working and inform more complex, multi-factorial risk assessments. The use of these models will also allow for better prioritisation of risk management interventions, and establishment of better food production techniques to limit the spread of AMR and promote good practice in the food chain.
View Project
Risk of AMR in the environment
United Kingdom - Public sector
This project developed a prioritisation approach to assess a range of different environmental scenarios for human exposure to microorganisms resistant to antimicrobials and hence compare their significance for human health.
View Project
Risk-based surveillance training to 90 veterinarians across Africa
Kenya, Rwanda, Mali, Benin - AU-IBAR
We conducted training courses for two solid months, working in 2 languages in 4 locations in Africa: Naivasha, Kenya; Kigali, Rwanda; Bamako, Maki; and Cotonou, Benin.
View Project
Shiny EpiTools
World wide - EpiMundi
A set of free calculators for planning, implementation and analysis of epidemiological studies, disease surveillance and evalution of diagnostic tests.
View Project
TRANSFORM: Market-driven risk mitigation
Indonesia, Vietnam, India, Kenya - USAID
A large and complex research project funded by USAID and conducted across 4 countries to explore market-driven approaches to risk mitigation.
View Project
Unlocking the Value of Veterinary Epidemiological Data: A New Standard for Reuse and Innovation
Europe - European Commission
EpiMundi’s research introduces new community-driven guidelines for creating rich, domain-specific metadata in veterinary epidemiology, aiming to transform isolated datasets into reusable assets by standardizing the reporting of data lineage, context, and quality. These standards address the limitations of generic data descriptions to enable effective data reuse for regulators, researchers, and industry.
View Project
Information Systems
World wide - Public and private sectors
We have been developing information systems and decision-support tools to strengthen industry, national, regional and global animal health and production systems for the last 25 years.
View Project
Training and workshop facilitation
World wide - Public and private sectors
We deliver engaging, customised short courses in a range of epidemiological skills areas to boost the confidence and capacities of animal health staff, teams and students around the world.
View Project